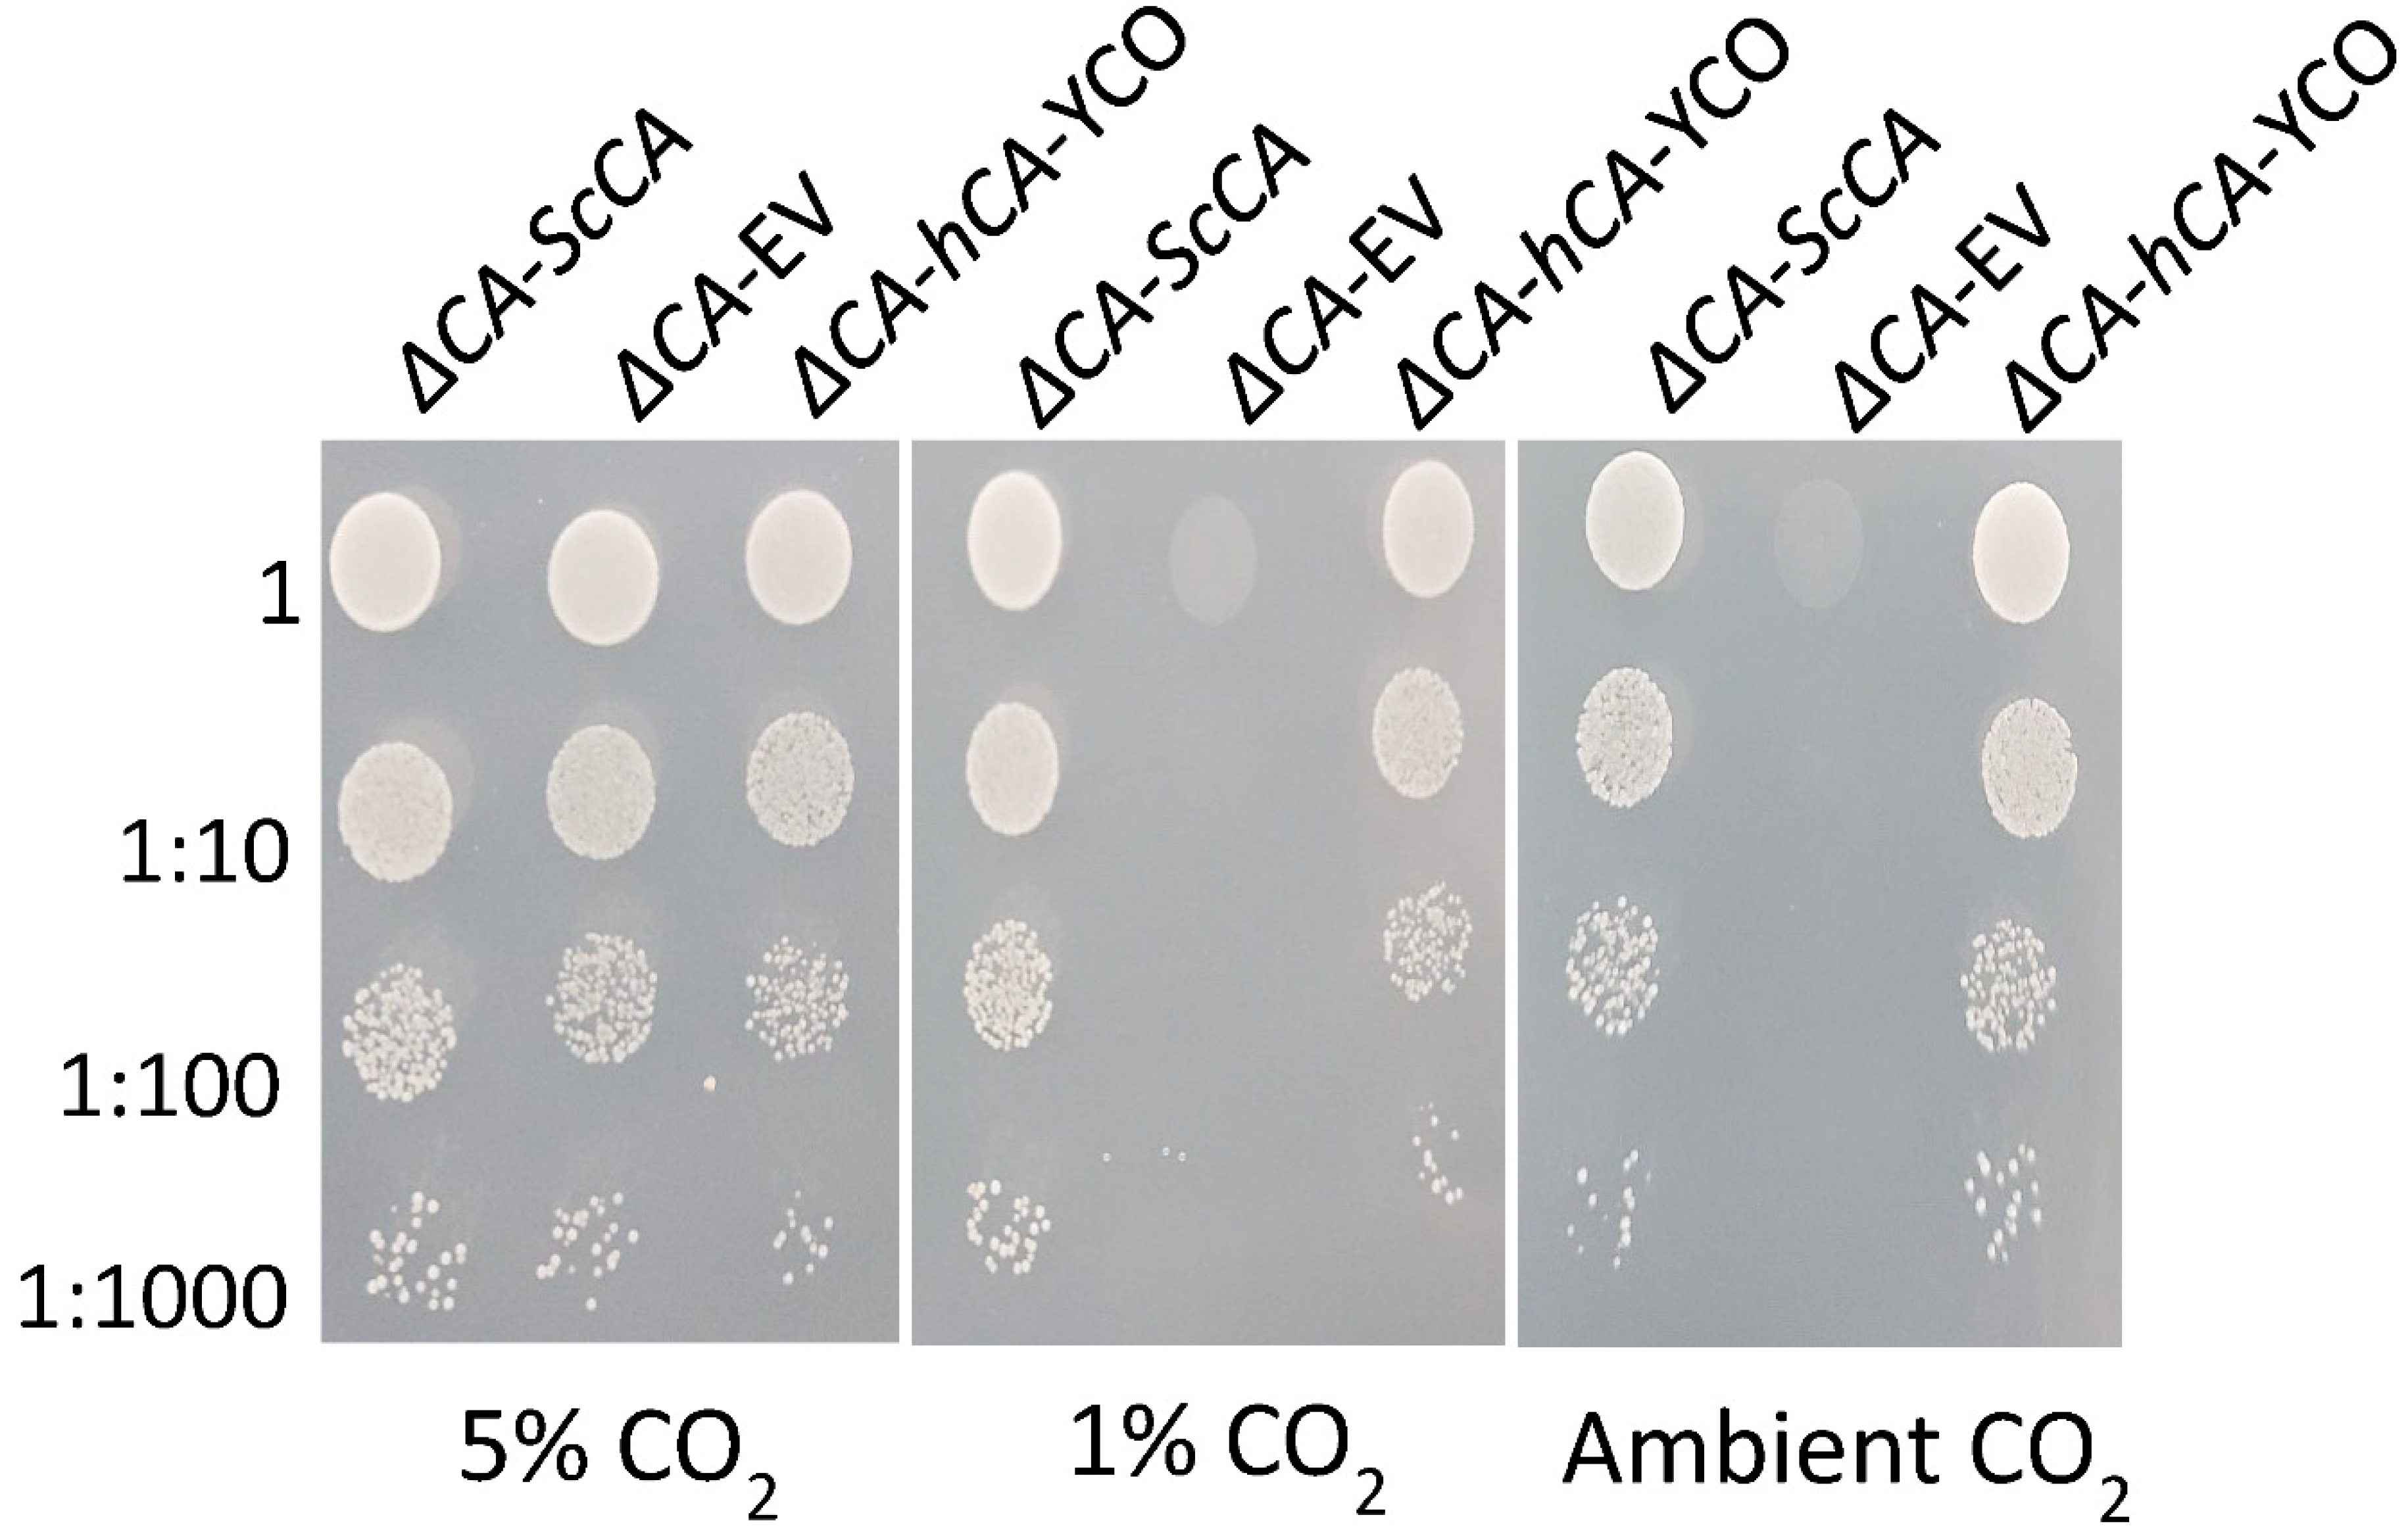
Plants 11 01882 g004 550
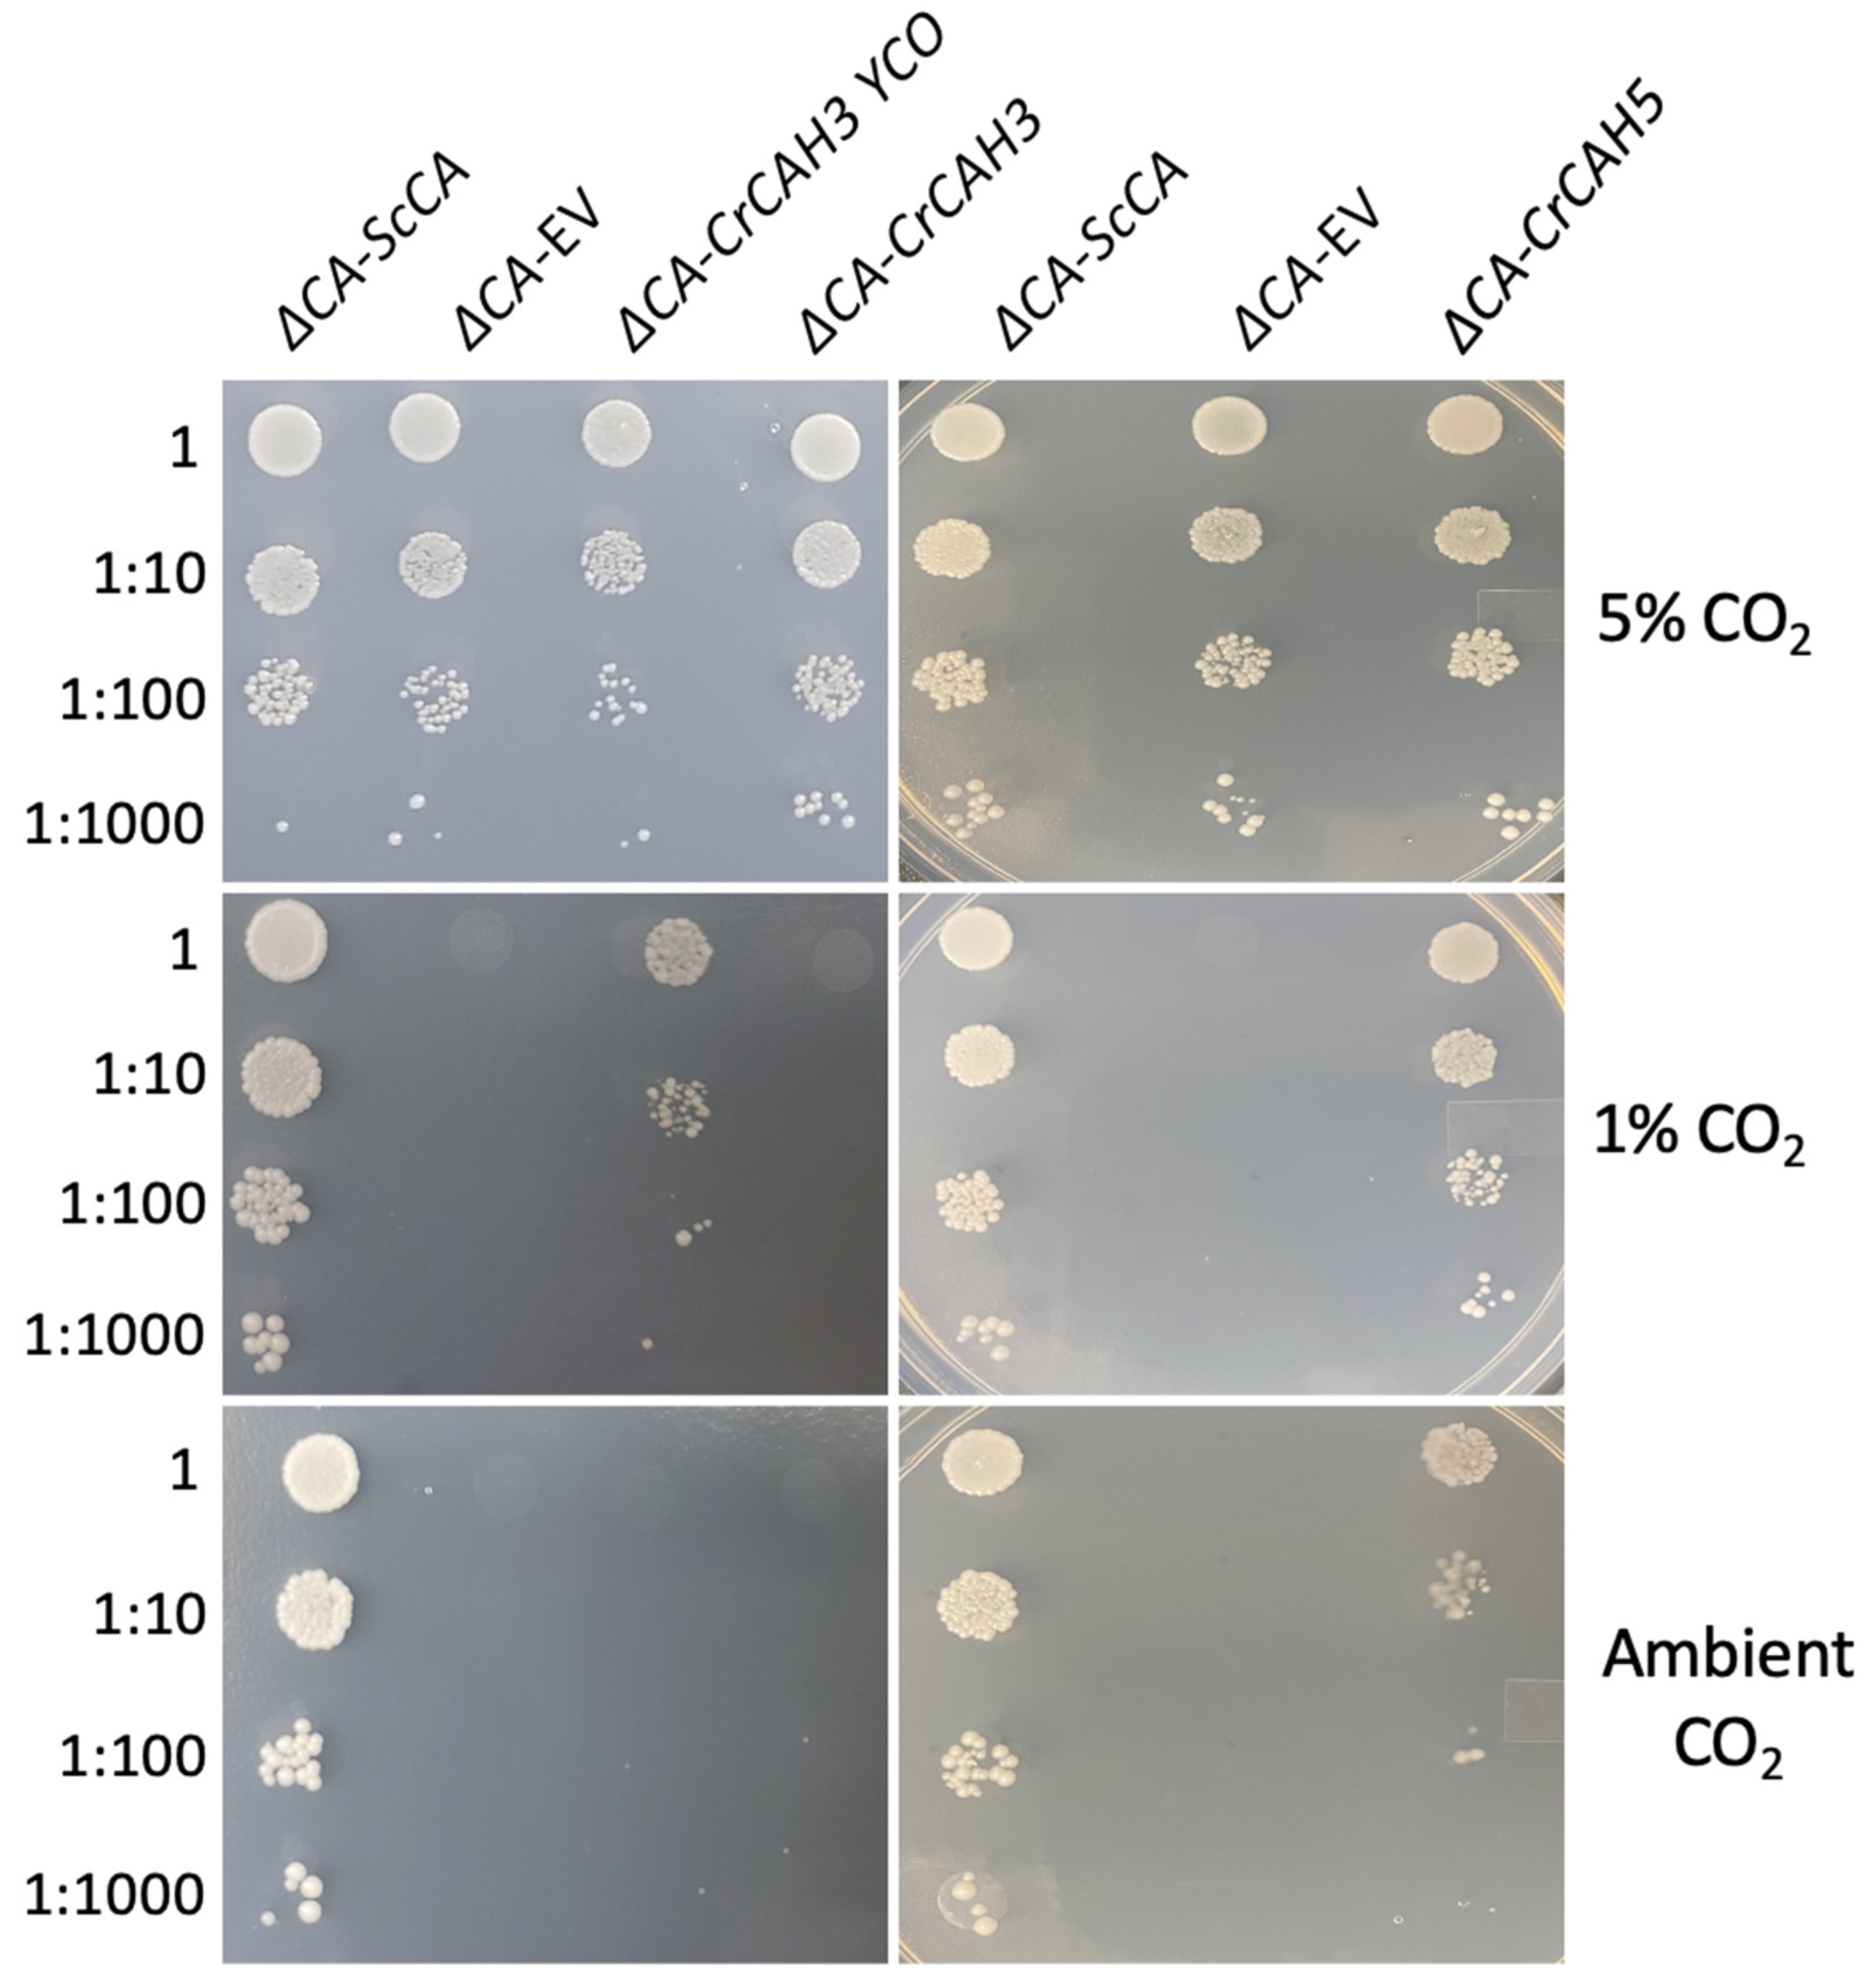
Plants 11 01882 g007 550

A Rapid Method for Detecting Normal or Modified Plant and Algal Carbonic Anhydrase Activity Using Saccharomyces cerevisiae
Abstract
:1. Introduction
2. Results
2.1. The S. cerevisiae Strain ΔCA Has a High-CO2-Dependent Growth Phenotype
2.2. ΔCA Can Be Used as a Heterologous Complementation System to Detect CA Activity of Normal and Modified CAs
2.3. Plant and Algal Carbonic Anhydrases Show CA Activity in ΔCA-Based Heterologous Complementation System
2.4. ΔCA-Based Heterologous Complementation System Can Be Used to Quantify CA Activity Using Wilbur–Anderson Assay and MIMS
3. Discussion
4. Materials and Methods
4.1. S. cerevisiae Strain and Growth Conditions
4.2. Generation of S. cerevisiae Carbonic Anhydrase Knock-Out
4.3. Genetic Constructs and Vectors
4.4. S. cerevisiae CA Knock-Out Transformation
4.5. High-CO2-Dependence Growth Assay
4.6. Immunological Detection of Expressed Proteins in S. cerevisiae
4.7. Analysis of Neutral Lipid Synthesis Using Radiolabel 14C-Acetic Acid
4.8. Carbonic Anhydrase Activity Assay
Supplementary Materials
Author Contributions
Funding
Institutional Review Board Statement
Informed Consent Statement
Data Availability Statement
Acknowledgments
Conflicts of Interest
References
- Supuran, C.T. Structure and function of carbonic anhydrases. Biochem. J. 2016, 473, 2023–2032. [Google Scholar] [CrossRef] [PubMed]
- DiMario, R.J.; Machingura, M.C.; Waldrop, G.L.; Moroney, J.V. The many types of carbonic anhydrases in photosynthetic organisms. Plant Sci. 2018, 268, 11–17. [Google Scholar] [CrossRef] [PubMed]
- Sültemeyer, D.; Schmidt, C.; Fock, H.P. Carbonic anhydrases in higher plants and aquatic microorganisms. Plant Physiol. 1993, 88, 179–190. [Google Scholar] [CrossRef]
- Moroney, J.V.; Ma, Y.; Frey, W.D.; Fusilier, K.A.; Pham, T.T.; Simms, T.A.; DiMario, R.J.; Yang, J.; Mukherjee, B. The carbonic anhydrase isoforms of Chlamydomonas reinhardtii: Intracellular location, expression, and physiological roles. Photosynth. Res. 2011, 109, 133–149. [Google Scholar] [CrossRef] [PubMed]
- Badger, M. The roles of carbonic anhydrases in photosynthetic CO2 concentrating mechanisms. Photosynth. Res. 2003, 77, 83. [Google Scholar] [CrossRef]
- Karlsson, J.; Clarke, A.K.; Chen, Z.Y.; Hugghins, S.Y.; Park, Y.I.; Husic, H.D.; Moroney, J.V.; Samuelsson, G. A novel alpha-type carbonic anhydrase associated with the thylakoid membrane in Chlamydomonas reinhardtii is required for growth at ambient CO2. EMBO J. 1998, 17, 1208–1216. [Google Scholar] [CrossRef] [Green Version]
- Espie, G.S.; Kimber, M.S. Carboxysomes: Cyanobacterial RubisCO comes in small packages. Photosynth. Res. 2011, 109, 7–20. [Google Scholar] [CrossRef]
- Price, G.D.; Coleman, J.R.; Badger, M.R. Association of carbonic anhydrase activity with carboxysomes isolated from the cyanobacterium Synechococcus PCC7942. Plant Physiol. 1992, 100, 784–793. [Google Scholar] [CrossRef] [Green Version]
- Hatch, M.D.; Burnell, J.N. Carbonic Anhydrase Activity in Leaves and Its Role in the First Step of C4 Photosynthesis. Plant Physiol. 1990, 93, 825–828. [Google Scholar] [CrossRef] [Green Version]
- DiMario, R.J.; Giuliani, R.; Ubierna, N.; Slack, A.D.; Cousins, A.B.; Studer, A.J. Lack of leaf carbonic anhydrase activity eliminates the C4 carbon-concentrating mechanism requiring direct diffusion of CO2 into bundle sheath cells. Plant Cell Environ. 2022, 45, 1382–1397. [Google Scholar] [CrossRef]
- DiMario, R.J.; Quebedeaux, J.C.; Longstreth, D.J.; Dassanayake, M.; Hartman, M.M.; Moroney, J.V. The Cytoplasmic Carbonic Anhydrases βCA2 and βCA4 Are Required for Optimal Plant Growth at Low CO2. Plant Physiol. 2016, 171, 280–293. [Google Scholar] [CrossRef] [PubMed] [Green Version]
- Medina-Puche, L.; Castelló, M.J.; Canet, J.V.; Lamilla, J.; Colombo, M.L.; Tornero, P. β-carbonic anhydrases play a role in salicylic acid perception in Arabidopsis. PLoS ONE 2017, 12, e0181820. [Google Scholar] [CrossRef] [PubMed] [Green Version]
- Hines, K.M.; Chaudhari, V.; Edgeworth, K.N.; Owens, T.G.; Hanson, M.R. Absence of carbonic anhydrase in chloroplasts affects C3 plant development but not photosynthesis. Proc. Natl. Acad. Sci. USA 2021, 118, e2107425118. [Google Scholar] [CrossRef]
- Atkinson, N.; Mao, Y.; Chan, K.X.; McCormick, A.J. Condensation of Rubisco into a proto-pyrenoid in higher plant chloroplasts. Nat. Commun. 2020, 11, 6303. [Google Scholar] [CrossRef] [PubMed]
- Hennacy, J.H.; Jonikas, M.C. Prospects for engineering biophysical CO2 concentrating mechanisms into land plants to enhance yields. Annu. Rev. Plant Biol. 2020, 71, 461–485. [Google Scholar] [CrossRef] [Green Version]
- Long, B.M.; Hee, W.Y.; Sharwood, R.E.; Rae, B.D.; Kaines, S.; Lim, Y.-L.; Nguyen, N.D.; Massey, B.; Bala, S.; von Caemmerer, S.; et al. Carboxysome encapsulation of the CO2-fixing enzyme Rubisco in tobacco chloroplasts. Nat. Commun. 2018, 9, 3570. [Google Scholar] [CrossRef] [Green Version]
- Amoroso, G.; Morell-Avrahov, L.; Müller, D.; Klug, K.; Sültemeyer, D. The gene NCE103 (YNL036w) from Saccharomyces cerevisiae encodes a functional carbonic anhydrase and its transcription is regulated by the concentration of inorganic carbon in the medium. Mol. Microbiol. 2005, 56, 549–558. [Google Scholar] [CrossRef]
- Aguilera, J.; Van Dijken, J.P.; De Winde, J.H.; Pronk, J.T. Carbonic anhydrase (Nce103p): An essential biosynthetic enzyme for growth of Saccharomyces cerevisiae at atmospheric carbon dioxide pressure. Biochem. J. 2005, 391, 311–316. [Google Scholar] [CrossRef] [Green Version]
- Whitney, P.A.; Cooper, T.G. Urea Carboxylase and Allophanate Hydrolase: Two components of adenosine triphosphate:urea amido-lyase in Saccharomyces cerevisisae. J. Biol. Chem. 1972, 247, 1349–1353. [Google Scholar] [CrossRef]
- Mishina, M.; Rogguenkamp, R.; Schweizer, E. Yeast mutants defective in acetyl-coenzyme A carboxylase and biotin: Apocarboxylase ligase. Eur. J. Biochem. 1980, 111, 79–87. [Google Scholar] [CrossRef]
- Magnuson, K.; Jackowski, S.; Rock, C.O.; Cronan, J.E. Regulation of fatty acid biosynthesis in Escherichia coli. Microbiol. Rev. 1993, 57, 522–542. [Google Scholar] [CrossRef] [PubMed]
- Rogers, S.; Henne, W.M. Analysis of Neutral Lipid Synthesis in Saccharomyces cerevisiae by Metabolic Labeling and Thin Layer Chromatography. J. Vis. Exp. 2021, 168, e62201. [Google Scholar] [CrossRef] [PubMed]
- Eriksson, M.; Karlsson, J.; Ramazanov, Z.; Gardeström, P.; Samuelsson, G. Discovery of an algal mitochondrial carbonic anhydrase: Molecular cloning and characterization of a low-CO2-induced polypeptide in Chlamydomonas reinhardtii. Proc. Natl. Acad. Sci. USA 1996, 93, 12031–12034. [Google Scholar] [CrossRef] [PubMed] [Green Version]
- Fang, W.; Si, Y.; Douglass, S.; Casero, D.; Merchant, S.S.; Pellegrini, M.; Ladunga, I.; Liu, P.; Spalding, M.H. Transcriptome-wide changes in Chlamydomonas reinhardtii gene expression regulated by carbon dioxide and the CO2-concentrating mechanism regulator CIA5/CCM1. Plant Cell 2012, 24, 1876–1893. [Google Scholar] [CrossRef] [PubMed] [Green Version]
- Rai, A.K.; Chen, T.; Moroney, J.V. Mitochondrial carbonic anhydrases are needed for optimal photosynthesis at low CO2 levels in Chlamydomonas. Plant Physiol. 2021, 187, 1387–1398. [Google Scholar] [CrossRef] [PubMed]
- Hanson, D.T.; Franklin, L.A.; Samuelsson, G.; Badger, M.R. The Chlamydomonas reinhardtii cia3 mutant lacking a thylakoid lumen-localized carbonic anhydrase is limited by CO2 supply to Rubisco and not photosystem II function in vivo. Plant Physiol. 2003, 132, 2267–2275. [Google Scholar] [CrossRef]
- Park, Y.-I.; Karlsson, J.; Rojdestvenski, I.; Pronina, N.; Klimov, V.; Öquist, G.; Samuelsson, G. Role of a novel photosystem II-associated carbonic anhydrase in photosynthetic carbon assimilation in Chlamydomonas reinhardtii. FEBS Lett. 1999, 444, 102–105. [Google Scholar] [CrossRef] [Green Version]
- Wilbur, K.M.; Anderson, N.G. Electrometric and colorimetric determination of carbonic anhydrase. J. Biol. Chem. 1948, 176, 147–154. [Google Scholar] [CrossRef]
- Clark, D.; Rowlett, R.S.; Coleman, J.R.; Klessig, D.F. Complementation of the yeast deletion mutant DeltaNCE103 by members of the beta class of carbonic anhydrases is dependent on carbonic anhydrase activity rather than on antioxidant activity. Biochem. J. 2004, 379, 609–615. [Google Scholar] [CrossRef]
- Sangkaew, A.; Krungkrai, J.; Yompakdee, C. Development of a high throughput yeast-based screening assay for human carbonic anhydrase isozyme II inhibitors. AMB Express 2018, 8, 124. [Google Scholar] [CrossRef]
- Dodgson, S.J.; Forster, R.E.; Schwed, D.A.; Storey, B.T. Contribution of matrix carbonic anhydrase to citrulline synthesis in isolated guinea pig liver mitochondria. J. Biol. Chem. 1983, 258, 7696–7701. [Google Scholar] [CrossRef]
- Hazen, S.A.; Waheed, A.; Sly, W.S.; Lanoue, K.F.; Lynch, C.J. Differentiation-dependent expression of CA V and the role of carbonic anhydrase isozymes in pyruvate carboxylation in adipocytes. FASEB J. 1996, 10, 481–490. [Google Scholar] [CrossRef]
- Nocentini, A.; Donald. W., A.; Supuran, C.T. Human carbonic anhydrases: Tissue distribution, physiological role, and druggability. In Carbonic Anhydrases; Academic Press: Cambridge, MA, USA, 2019; pp. 151–185. [Google Scholar]
- Lacroute, F.; Piérard, A.; Grenson, M.; Wiame, J.M. The biosynthesis of carbamoyl phosphate in Saccharomyces cerevisiae. Microbiology 1965, 40, 127–142. [Google Scholar]
- Roggenkamp, R.; Numa, S.; Schweizer, E. Fatty acid-requiring mutant of Saccharomyces cerevisiae defective in acetyl-CoA carboxylase. Proc. Natl. Acad. Sci. USA 1980, 77, 1814–1817. [Google Scholar] [CrossRef] [PubMed] [Green Version]
- Long, S.P.; Marshall-Colon, A.; Zhu, X.G. Meeting the global food demand of the future by engineering crop photosynthesis and yield potential. Cell 2015, 161, 56–66. [Google Scholar] [CrossRef] [PubMed] [Green Version]
- McGrath, J.M.; Long, S.P. Can the cyanobacterial carbon-concentrating mechanism increase photosynthesis in crop species? A Theoretical Analysis. Plant Physiol. 2014, 164, 2247–2261. [Google Scholar] [CrossRef] [Green Version]
- Moroney, J.V.; Tolbert, N.E.; Sears, B.B. Complementation analysis of the inorganic carbon concentrating mechanism of Chlamydomonas reinhardtii. Mol. Gen. Genet. MGG 1986, 204, 199–203. [Google Scholar] [CrossRef]
- Spalding, M.H.; Spreitzer, R.J.; Ogren, W.L. Reduced inorganic carbon transport in a CO2-requiring mutant of Chlamydomonas reinhardii. Plant Physiol. 1983, 73, 273–276. [Google Scholar] [CrossRef] [Green Version]
- Benlloch, R.; Shevela, D.; Hainzl, T.; Grundström, C.; Shutova, T.; Messinger, J.; Samuelsson, G.; Sauer-Eriksson, A.E. Crystal structure and functional characterization of photosystem II-associated carbonic anhydrase CAH3 in Chlamydomonas reinhardtii. Plant Physiol. 2015, 167, 950–962. [Google Scholar] [CrossRef] [Green Version]
- Blanco-Rivero, A.; Shutova, T.; Román, M.J.; Villarejo, A.; Martinez, F. Phosphorylation controls the localization and activation of the lumenal carbonic anhydrase in Chlamydomonas reinhardtii. PLoS ONE 2012, 7, e49063. [Google Scholar] [CrossRef] [Green Version]
- Gueldener, U.; Heinisch, J.; Koehler, G.J.; Voss, D.; Hegemann, J.H. A second set of loxP marker cassettes for Cre-mediated multiple gene knockouts in budding yeast. Nucleic Acids Res. 2011, 30, e23. [Google Scholar] [CrossRef] [PubMed] [Green Version]
- Sikorski, R.S.; Hieter, P. A system of shuttle vectors and yeast host strains designed for efficient manipulation of DNA in Saccharomyces cerevisiae. Genetics 1989, 122, 19–27. [Google Scholar] [CrossRef] [PubMed]
- Alberti, S.; Gitler, A.D.; Lindquist, S. A suite of Gateway® cloning vectors for high-throughput genetic analysis in Saccharomyces cerevisiae. Yeast 2007, 24, 913–919. [Google Scholar] [CrossRef] [PubMed] [Green Version]
- Gietz, R.D.; Schiestl, R.H. Frozen competent yeast cells that can be transformed with high efficiency using the LiAc/SS carrier DNA/PEG method. Nat. Protoc. 2007, 2, 1–4. [Google Scholar] [CrossRef] [PubMed]
- Zhang, T.; Lei, J.; Yang, H.; Xu, K.; Wang, R.; Zhang, Z. An improved method for whole protein extraction from yeast Saccharomyces cerevisiae. Yeast 2011, 28, 795–798. [Google Scholar] [CrossRef]
- Mitra, M.; Lato, S.M.; Ynalvez, R.A.; Xiao, Y.; Moroney, J.V. Identification of a new chloroplast carbonic anhydrase in Chlamydomonas reinhardtii. Plant Physiol. 2004, 135, 173–182. [Google Scholar] [CrossRef] [Green Version]
- Price, G.D.; Badger, M.R. Expression of human carbonic anhydrase in the canobacterium Synechococcus PCC7942 creates a high CO2-requiring phenotype: Evidence for a central role for carboxysomes in the CO2 concentrating mechanism. Plant Physiol. 1989, 91, 505–513. [Google Scholar] [CrossRef] [Green Version]

| Biochemical Trait | ΔCA-hCA-YCO | ΔCA-hCA-YCO AcV5 | ΔCA-hCA-Atex | ΔCA-hCA-Atex AcV5 | ΔCA-hCA-YCO eGFP | ΔCA-hCA-Atex eGFP | ΔCA-EV | ΔCA-ScCA |
|---|---|---|---|---|---|---|---|---|
| Specific activity | 4.7 ± 0.5 WAU mg−1 | 3.9 ± 0.4 WAU mg−1 | 1.9 ± 0.2 WAU mg−1 | 0.9 ± 0.1 WAU mg−1 | 2.5 ± 0.3 WAU mg−1 | 1.4 ± 0.2 WAU mg−1 | 0.9 ± 0.1 WAU mg−1 | 1.2 ± 0.1 WAU mg−1 |
Publisher’s Note: MDPI stays neutral with regard to jurisdictional claims in published maps and institutional affiliations. |
© 2022 by the authors. Licensee MDPI, Basel, Switzerland. This article is an open access article distributed under the terms and conditions of the Creative Commons Attribution (CC BY) license (https://creativecommons.org/licenses/by/4.0/).
Share and Cite
Rai, A.K.; DiMario, R.J.; Kasili, R.W.; Groszmann, M.; Cousins, A.B.; Donze, D.; Moroney, J.V. A Rapid Method for Detecting Normal or Modified Plant and Algal Carbonic Anhydrase Activity Using Saccharomyces cerevisiae. Plants 2022, 11, 1882. https://doi.org/10.3390/plants11141882
Rai AK, DiMario RJ, Kasili RW, Groszmann M, Cousins AB, Donze D, Moroney JV. A Rapid Method for Detecting Normal or Modified Plant and Algal Carbonic Anhydrase Activity Using Saccharomyces cerevisiae. Plants. 2022; 11(14):1882. https://doi.org/10.3390/plants11141882
Chicago/Turabian StyleRai, Ashwani K., Robert J. DiMario, Remmy W. Kasili, Michael Groszmann, Asaph B. Cousins, David Donze, and James V. Moroney. 2022. "A Rapid Method for Detecting Normal or Modified Plant and Algal Carbonic Anhydrase Activity Using Saccharomyces cerevisiae" Plants 11, no. 14: 1882. https://doi.org/10.3390/plants11141882
APA StyleRai, A. K., DiMario, R. J., Kasili, R. W., Groszmann, M., Cousins, A. B., Donze, D., & Moroney, J. V. (2022). A Rapid Method for Detecting Normal or Modified Plant and Algal Carbonic Anhydrase Activity Using Saccharomyces cerevisiae. Plants, 11(14), 1882. https://doi.org/10.3390/plants11141882

